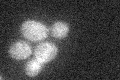
YKL213C
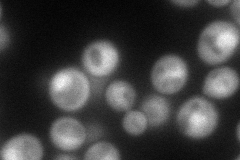
YKL213C
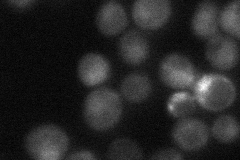
YKL213C
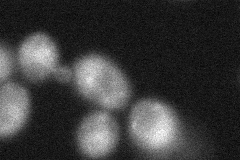
YKL213C
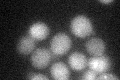
YKL213C
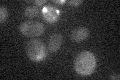
YKL213C

View description
WD repeat protein required for ubiquitin-mediated protein degradation, forms complex with Cdc48p, plays a role in controlling cellular ubiquitin concentration; also promotes efficient NHEJ in postdiauxic/stationary phase
Localization:
Intensity:
Fold change:
Significance:
-
C’ GFP library in SD
below threshold17.11 -
N' NOP1pr-GFP in SD
cytosol,nucleus102.834 -
N' TEF2pr-mCherry in SD

nucleus125.015 -
N' NATIVEpr-GFP in SD
nucleus35.2383 -
N' TEF2pr-VC and Cyto-VN in SD
cytosol43.8783 -
C’ GFP library in SD+DTT
cytosol13.440.78No -
C’ GFP library in SD+H2O2

cytosol22.551.31No -
C’ GFP library in Starvation Media
cytosol14.370.83No -
C’ GFP library on the background of Pup2-DaMP

below threshold -
C’ GFP library on the background of CCT mutant

below threshold19.82611.15781No
